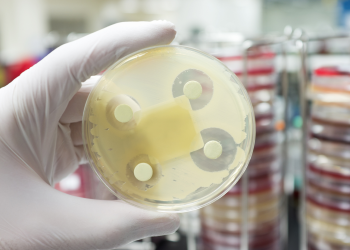

A previsibilidade na vitivinicultura – e os diferentes impactos na resiliência da região do Douro – valeu ao projeto Wine4Cast o Prémio + Sustentabilidade
O clima constitui um fator de incerteza e risco para os diferentes atores deste setor estratégico para a economia nacional. ...

Notícias, atualidade, curiosidades e muito mais sobre o INESC TEC e a sua comunidade!